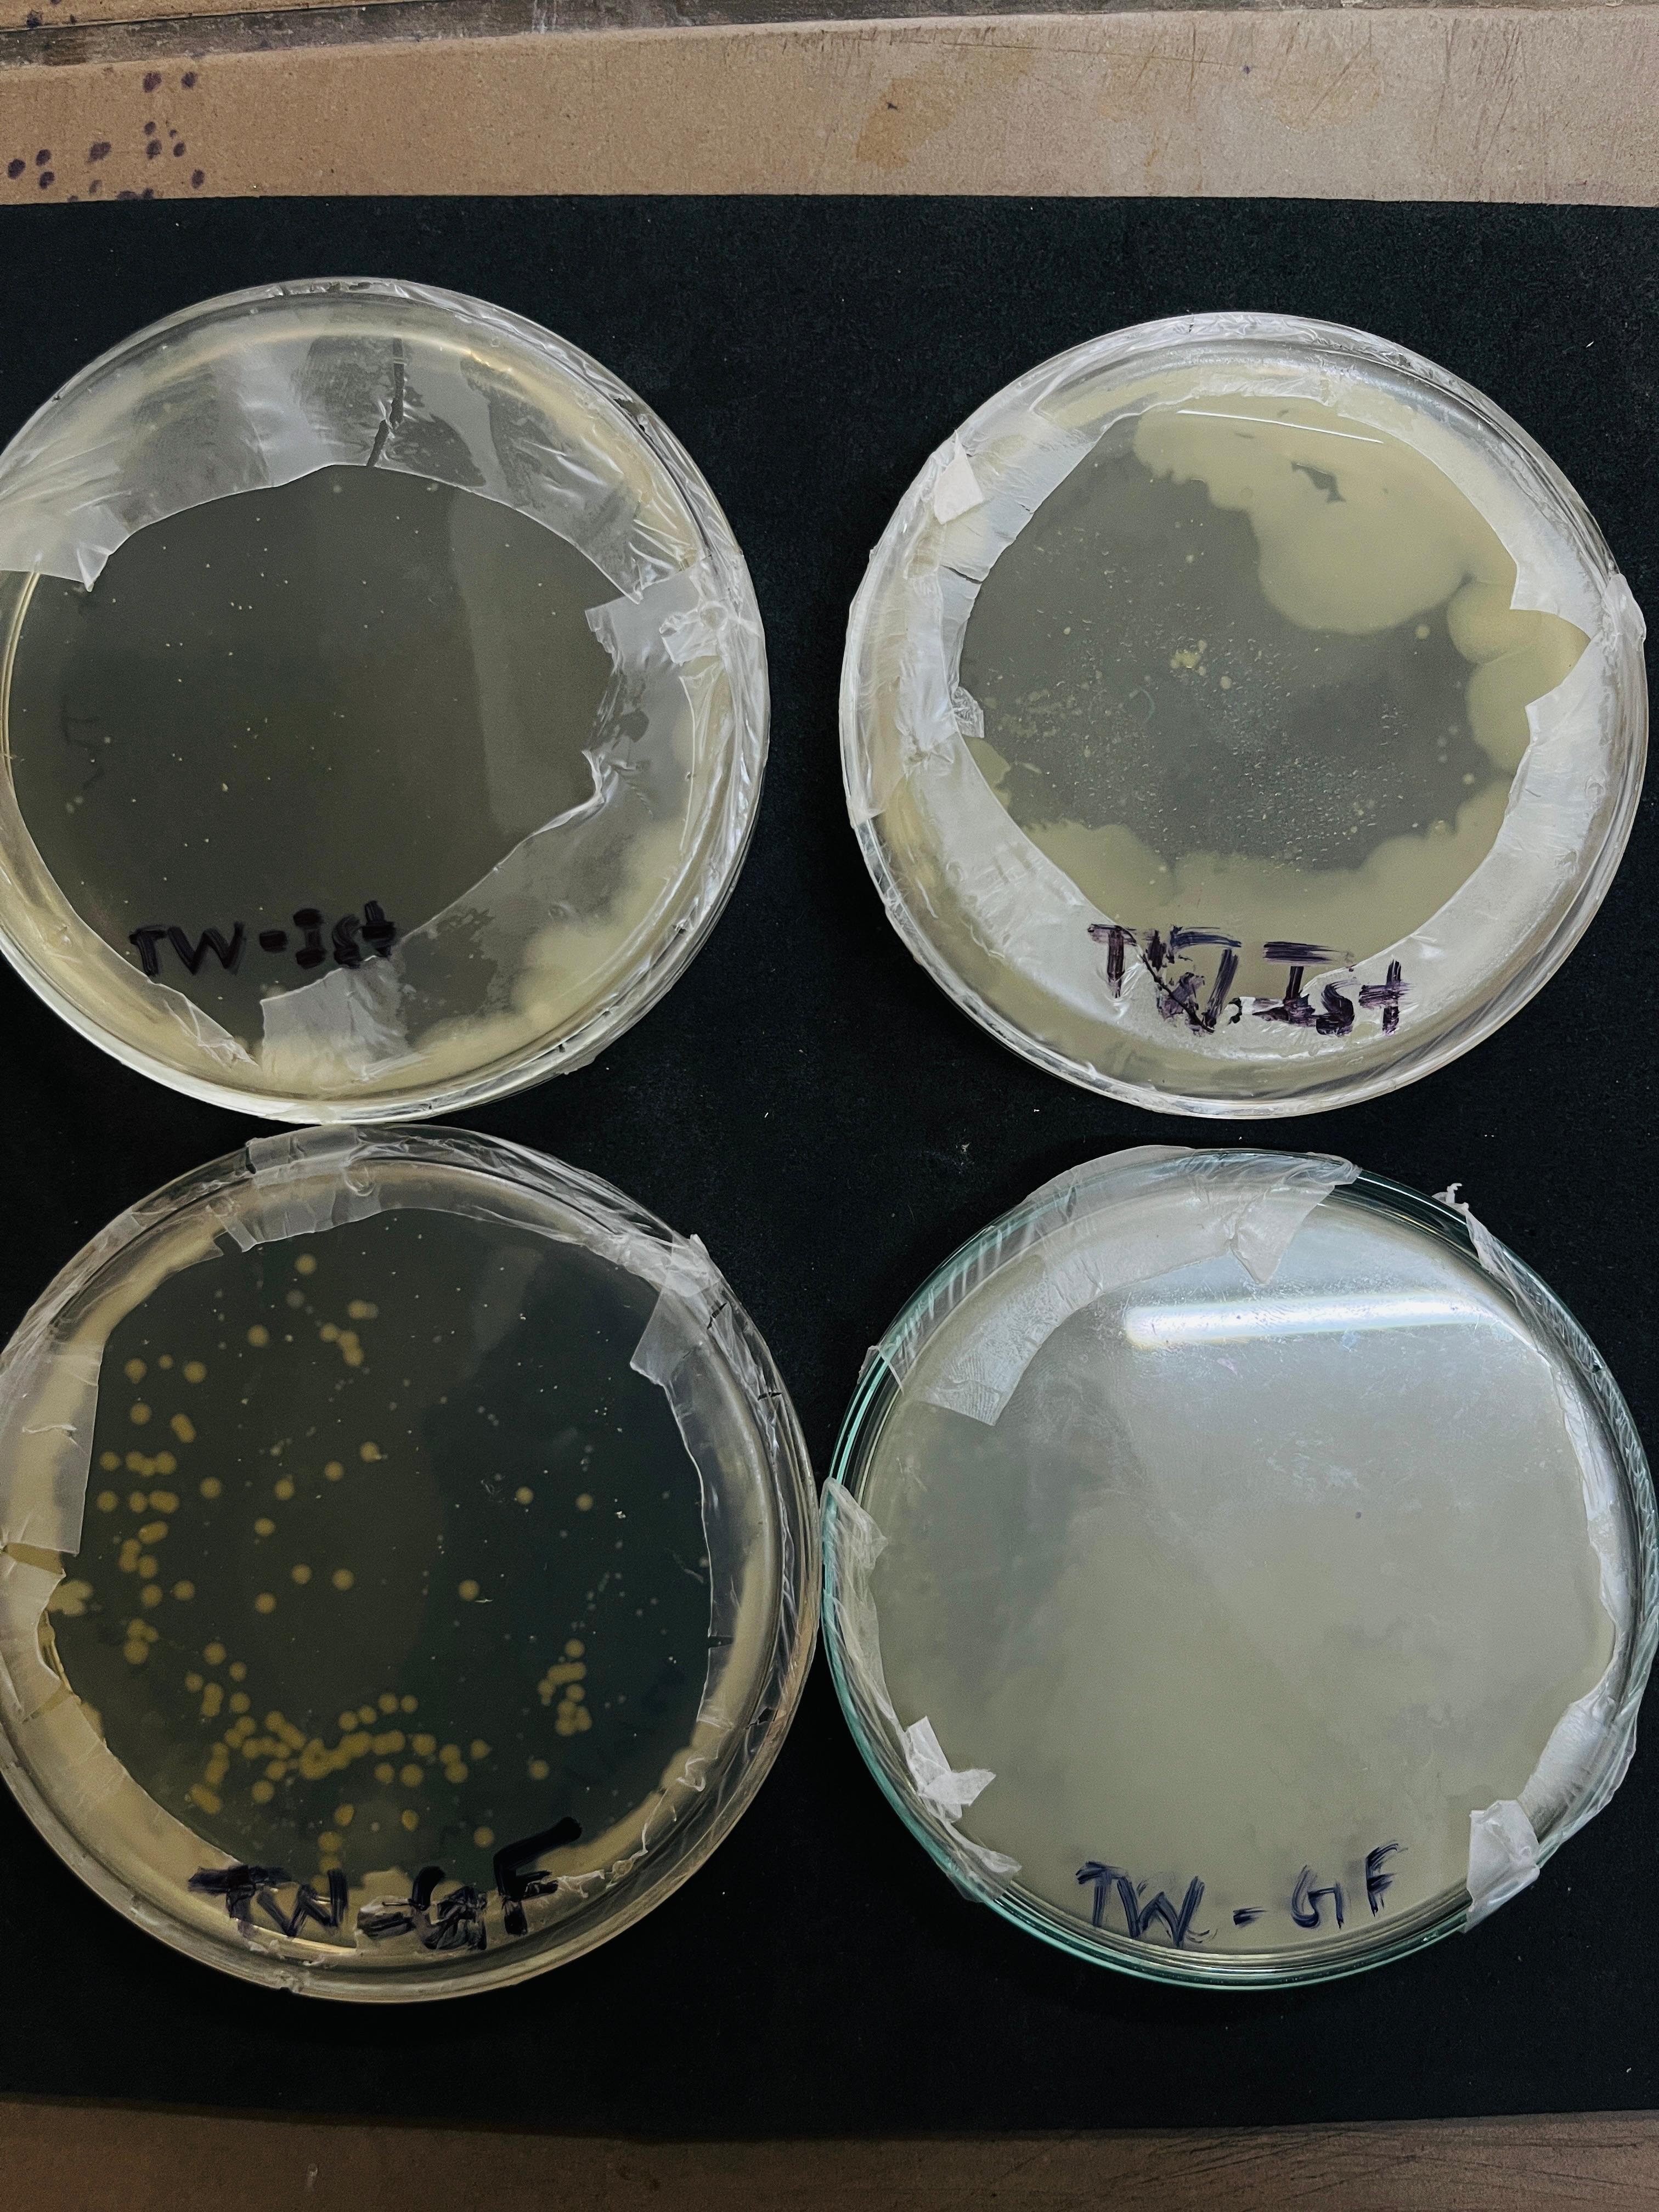
UIET Kurukshetra Facilities & Labs photo (9) by Deepanshu Kaushik
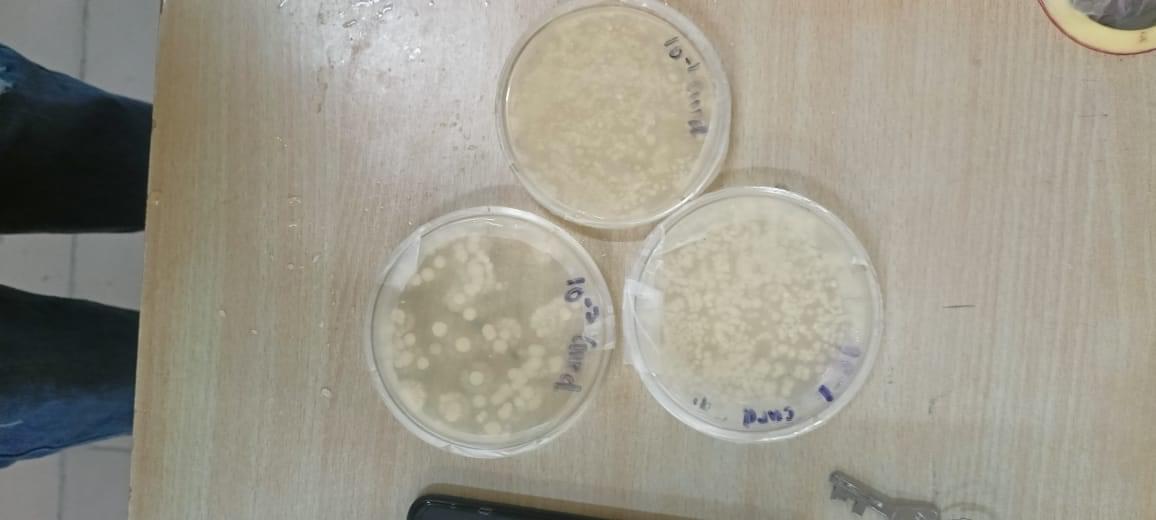
UIET Kurukshetra Facilities & Labs photo (10) by Deepanshu Kaushik
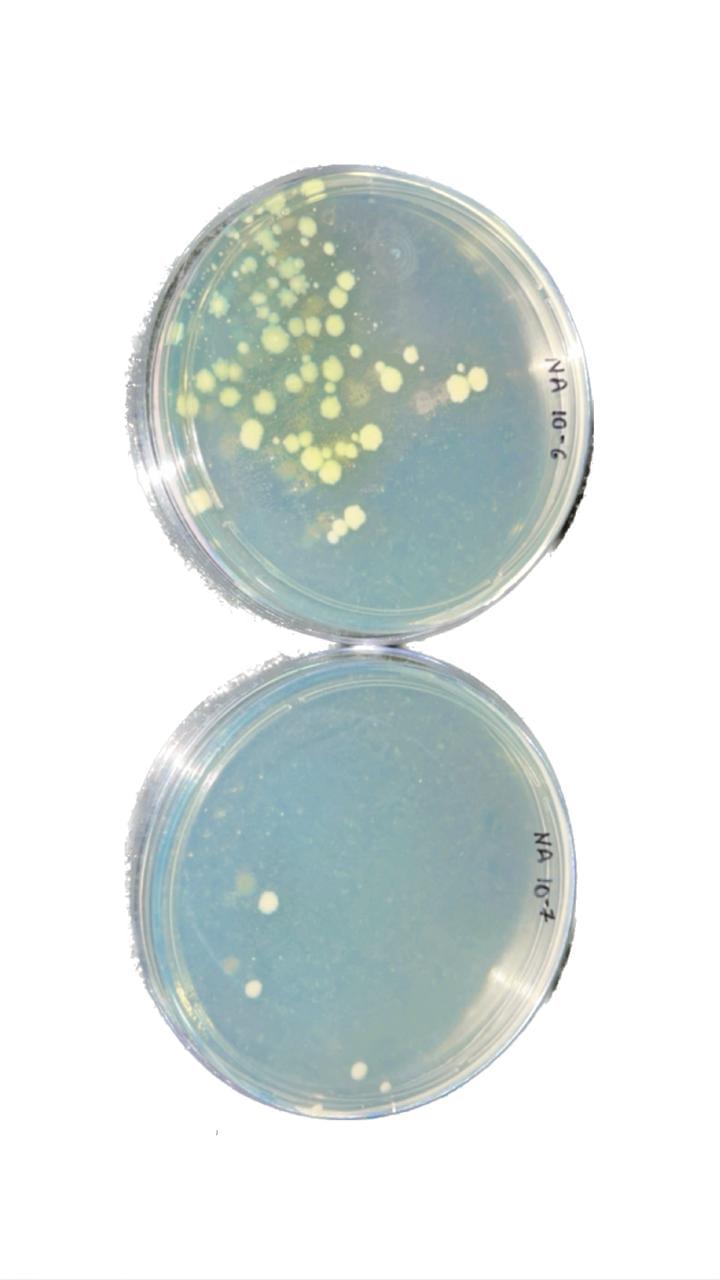
UIET Kurukshetra Facilities & Labs photo (11) by Deepanshu Kaushik
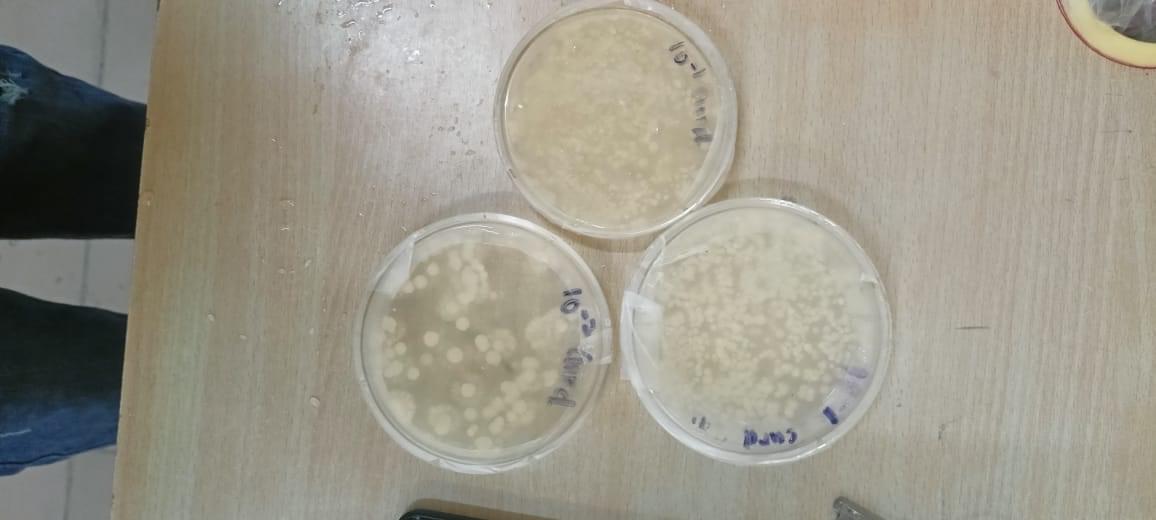
UIET Kurukshetra Facilities & Labs photo (12) by Deepanshu Kaushik

UIET Kurukshetra Gallery
Student Snapshots

Extra-Curricular

Extra-Curricular

Hostels

Campus

Convocation & Festivals

Facilities & Labs

Facilities & Labs

Facilities & Labs

Facilities & Labs

General

General

General

General

Extra-Curricular

Extra-Curricular

Extra-Curricular

Extra-Curricular

Extra-Curricular

Hostels

Hostels
UIET Kurukshetra Gallery
UIET Images





Facilities






Important Updates
Why To Join UIET Kurukshetra - Reviews & Rating












Most Popular Tags
Reset All Filter

Campus Life:
Yes there are many fests in our college like diwali hatt, ratnawali etc but they are not as great as no big star comes there for the fest but due to kurukshetra as district there is gita mohtsav. There are some books but all are of our field of like our subjects syllabus. Facilities are provided like fan, bulb, whiteboard and some classes also have projectors which is overall ok. Almost all basic games and sports are present like kabaddi, cricket, football, chess, carrom etc. Yes there are many clubs like literacy, dance, music, photography, environmental , etc.
0
0
Reply
Report

Campus Life:
the social life is quite good.
there's a fest which is held every october named diwali haat which is really cool.
a wide range of easily accessible books are available in the library.
classrooms are equipped with projectors which is quitre good.
you can participate in athletics, cricket, basketball, volleyball, boxing etc
a student run club is GDG or google developer group which offers workshops and technical talks for students.
0
0
Reply
Report
Campus Life:
The infrastructure here is very bad and the building is too old and basic the clubs are also pretty average but bearable events here are close to none also there is no sports activities here the facilities inside the classroom are close to none but I must say the books facility are good
0
1
Reply
Report

Student Snaps:




Campus Life:
there are many fests like geeta mahautsaaav . confluence ,exciller , diwali haat
there are very good library . two library are there. all books are available,
room are ok. but most rooms are not having ac
all sports are available
there are elections also for students organisations
0
0
Reply
Report
College Ninja
Reviewed on Dec 29, 2024(Enrolled 2023)Campus Life:
We recently jad Diwali fest in october, which was organized bu UIET, KUK itself. it was great fest, and we enjoyed a lot too. We have every required book in our college, but it's like first come first serve. If you go after 2-3 days of the given date for book issue, you will not have any book, they're gone. We need more books in library. Not much of sports or extra curricular activities happen. Excelsior is the only fest that happens, but there's no news when will it take place! Yess we do have many clubs and students can join it. Usually seniors handles these clubs,but every club have a respective teacher too. WE have clubs like dance club, music club, adventure club and more technical clubs, etc. we also have NCC.
0
0
Reply
Report

Campus Life:
The campus life is pretty good and there are severesl techical and annual fest occur in the university every year. Almost all the books and journals are available in the library. There are also many sports facilities available in the university
0
0
Reply
Report

Campus Life:
Ratnawali, exelcisor, awahaan, diwali baat are the annual and technical festival that are typically held There are various books and resources for various subjects available in our library
Our classroom
0
0
Reply
Report

Campus Life:
Overall experience , I will say it was great. Students and proffesors are very interactive. There are lots of clubs related to education and co-curricular activities. The infrastucture is also very nice. The technologies provided in the lab are top notch. The student portal is also useful and very much interactive.
0
0
Reply
Report

Campus Life:
the overall experience is not so good . there is not as such fests or any cultural programs in university. the life is very boring you have lot of time in a day .the library is very small in college . there are not so much advanced labs .in programming labs ,there are half computers that didnt work.
0
0
Reply
Report
Student Snaps:

Campus Life:
Excelsior is annual fest
Monthly fests student induction program ,Agman for first year students are organized
Awahan , pratispradha ,kshitiz various other fests are organized various technical non technical are held
Various clubs are there maths,science, arts,music,dance,promotion,sports,branchwise clubs many more
Social groups like NSS , REDCROSS ARE THERE
ncc are also there
And have a great effect in students life along with studies
0
0
Reply
Report
Do you think the data is wrong ? Report Here
UIET Kurukshetra Latest News
Kurukshetra University PhD Round 2 Admission 2026 Begins; Apply by March 2 @kuk.ac.in

Written BySapnaon Feb 20, 2026
 (1).png?h=78&w=78&mode=stretch)
Documents Required for JEE Main 2026 Exam Centre: Complete Guide

Written ByShivam Yadavon Mar 31, 2026

List of M.Tech Colleges without GATE 2026, Eligibility, Admission Process

Written ByBhaskar Dason Feb 18, 2026
.png?h=78&w=78&mode=stretch)
Discover More Colleges




Department of Instrumentation Technology Kurukshetra University
Kurukshetra
2.3(2)
₹69166First year Fees


International Institute of Engineering and Technology Kurukshetra
Kurukshetra
4.8(2)
₹50000First year Fees


Shri Krishan Institute of Engineering & Technology Kurukshetra
Kurukshetra
3.2(11)
₹66670First year Fees


Technology Education and Research Integrated Institute Kurukshetra
Kurukshetra
4(35)
₹98910First year Fees




![University Institute of Engineering and Technology - [UIET]](https://image-static.collegedunia.com/public/college_data/images/logos/1394860621University Institute of Engineering and Technology (UIET).png?h=71.7&w=71.7&mode=stretch)





 (1).png?h=72&w=72&mode=stretch)

.png?h=72&w=72&mode=stretch)



















Comments